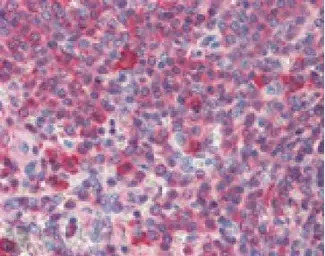
产品细节图片2

相关产品推荐更多 >
万千商家帮你免费找货
0 人在求购买到急需产品
- 详细信息
- 文献和实验
- 技术资料
- 免疫原:
Human Hsp90 purified from therapeutic orchiectomy specimens.
- 亚型:
IgG2a
- 形态:
Liquid
- 保存条件:
Store as concentrated solution. Centrifuge briefly prior to opening vial. For short-term storage (1-2 weeks), store at 4ºC. For long-term storage, aliquot and store at -20ºC or below. Avoid multiple freeze-thaw cycles.
- 克隆性:
Monoclonal
- 标记物:
Unconjugated
- 适应物种:
Human, Mouse, Rat, Sheep, Drosophila, Bovine, Dog, Hamster, Guinea pig, Pig, Monkey, Carp, Rainbow trout
- 保质期:
12 months from the shipping date of the product.
- 抗原来源:
Human
- 目录编号:
GTX13494
- 级别:
Primary Antibodies
- 库存:
Available
- 供应商:
GeneTex
- 宿主:
Rat
- 应用范围:
WB, ICC/IF, IHC-P, IP, EIA, IHC
- 浓度:
1 mg/ml (Please refer to the vial label for the specific concentration.)
- 靶点:
Detects both the alpha and beta isoforms of Hsp90
- 抗体英文名:
Hsp90 antibody [16F1]
- 抗体名:
Hsp90 抗体 [16F1]
- 规格:
100 μg

Western blot analysis of HSP90: Lane 1: MW marker, Lane 2: HSP90 native protein, Lane 3: HSP90b recombinant protein, Lane 4: HSP90alpha recombinant protein, Lane 5: HeLa , Lane 6: L-929 , Lane 7: Rat-2 , Lane 8:RK-13.
Immunohistochemistry (paraffin sections) analysis of human spleen tissue stained with HSP90, mAb (16F1) at 10μg/ml.
风险提示:丁香通仅作为第三方平台,为商家信息发布提供平台空间。用户咨询产品时请注意保护个人信息及财产安全,合理判断,谨慎选购商品,商家和用户对交易行为负责。对于医疗器械类产品,请先查证核实企业经营资质和医疗器械产品注册证情况。
 文献和实验
文献和实验Espallergues J et al., J Neurosci 2012 (PMID:22457490)
Lee EJ et al., Sci Rep 2021 (PMID:34381136)
上海西唐生物科技有限公司 021-55229872, 65333639 www.westang.com 人热休克蛋白90 ( HSP90 )ELISA 试剂盒 原理 本实验采用双抗体夹心 ABC-ELISA 法。用抗人 HSP90 单抗包被于酶标板上,标准品和样品中的 HSP90与单抗结合,加入生物素化的抗人 HSP90 ,形成免疫复合物连接在板上,辣根
多篇 SCI 发现用 RIPA 提蛋白存在问题,我们该如何应对?
7 [3](下图),表明用 RIPA 裂解液提取这些特定蛋白质的效率十分低。近年来,越来越多的研究者密切关注 RIPA 不可溶组分中的蛋白质组分,以及它们对下游实验和整体数据的影响。Bai 和 Laiho 用 RIPA 裂解液从 Hela 细胞核中提取蛋白,发现可溶性组分和不可溶性组。分的蛋白质图谱差异很大,表明蛋白质的丢失不成正比 [4] (下图)。Mukhopadhyay 等 [5] 从突变小鼠的乳腺上皮细胞中提取总蛋白,发现在 RIPA 不可溶组分中,通过 WB 很容易检测到 EGFR, HSP90
=1&tpg=15&age=0 15.求助 蛋白的末端酰胺化用什么酶 http://www.dxy.cn/bbs/post/view?bid=65&id=4519314&sty=1&tpg=16&age=0 16.菜鸟求助:脂蛋白中氨基酸测序问题 http://www.dxy.cn/bbs/post/view?bid=65&id=4519267&sty=1&tpg=16&age=0 17.【求助】有人用过Invitrogen的Anti-myc antibody和Anti-myc-HRP
 技术资料
技术资料暂无技术资料 索取技术资料





![EAPII antibody [TDP2/1258]](https://img1.dxycdn.com/2023/0711/451/6106825198874858761-14.jpg!wh200)



